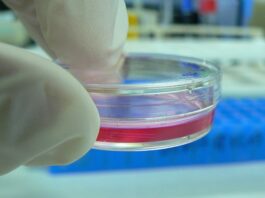
Utilizan microondas y ensayan una terapia localizada para atacar tumores Ensayo de laboratorio con una técnica para eliminar tumores

Los días 15 y 16 de septiembre 2022 el Campus Resistencia de la UNNE recibirá presencialmente a docentes e investigadorxs de distintas regiones del...
Desde el Instituto Nacional de Tecnología Industrial se organizan ensayos ITL Organización de Interlaboratios de empresas e instituciones del país. Dos laboratorios de la...
Buscarán formar a pacientes y usuarios/as en la conformación de aceites medicinal de cannabis. Trabajarán exclusivamente con personas inscriptas en el Registro Nacional del...
Un proyecto del Instituto de Botánica del Nordeste (UNNE-CONICET) buscará conocer el aporte de la vegetación nativa y/o exótica al espectro polínico atmosférico de...
Una investigación de la UNNE estudia la composición de nutrientes elementales en distintos alimentos de interés regional, como carne de pescado de río y...
Una investigación de la UNNE y CONICET, en articulación con el Instituto de Productos Lácteos de Asturias (CSIC) de España, avanza en la selección...
Más de 80 estudiantes de las tres carreras visitaron las casas de los vecinos del barrio Serantes para encuestar y obtener datos estadísticos de...
Dra. Mirta Mierez, directora del Centro Nacional de Parasitología y Enfermedades Tropicales (CENPETROP)
La prevención es la clave para evitar la enfermedad.
El 26 de agosto...
Se trata de “En camino hacia una alimentación saludable y nutritiva” a cargo de la docente e investigadora Sonia Sgroppo y está destinada a...
Convocados por la Secretaria General de Ciencia y Técnica, doctora Laura Leiva, directores de proyectos de I+D en ejecución participaron de un encuentro en...